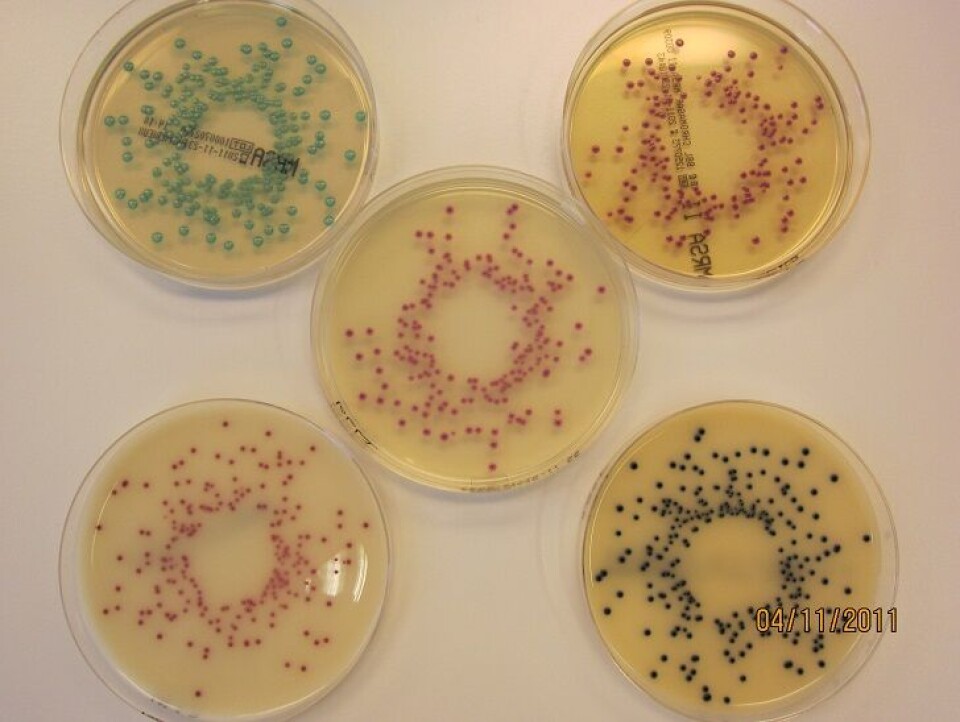
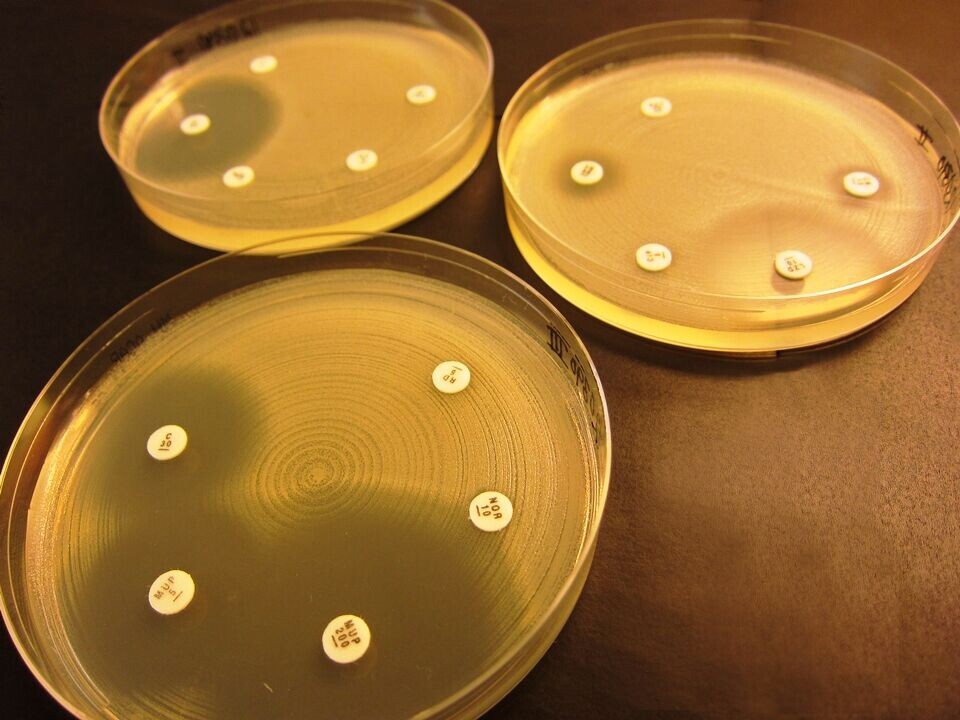

FAG i praksis

MRSA – et økende helseproblem
Meticillinresistente gule stafylokokker (MRSA) er et økende helseproblem både i Norge og resten av Europa, men Norge har fremdeles lav forekomst. Nasjonalt referanselaboratorium for MRSA ved St. Olavs hospital holder oversikt over situasjonen.
Innledning
Meticillinresistente gule stafylokokker (MRSA) kan gi en rekke ulike infeksjoner hos mennesker og dyr, men forekommer også ofte som asymptomatisk bærertilstand.
MRSA utgjør et helseproblem fordi resistensen vanskeliggjør valg av korrekt behandling. De medikamentene som egner seg for behandling har flere og mer alvorlige bivirkninger enn betalaktamantibiotika, både for pasienter og miljø. Mikroben blir derfor overvåket nøye.
De skandinaviske landene og Nederland har så langt hatt svært lav forekomst.
De fleste industrialiserte land har etablert nasjonale referanselaboratorier som kartlegger forekomst og utbredelse av MRSA.
1. januar 2006 ble det norske nasjonale referanselaboratoriet for MRSA etablert ved Avdeling for medisinsk mikrobiologi, St. Olavs hospital, Trondheim.
Etableringen skjedde på oppdrag fra Helse- og Omsorgsdepartementet.
Referanselaboratoriet har en stammebank av MRSA som ble etablert i mai 2005. Den ble komplett fra januar 2008, da alle medisinsk mikrobiologiske laboratorier ble pålagt å sende inn alle nypåviste MRSA.
MRSA i Norge
Foreløpig antall nypåviste MRSA for 2011 (per 24.01.12) er 984. Det er en økning på 7,2 prosent sammenliknet med tallene fra 2010. Det forventes at dette tallet kommer til å øke ytterligere på grunn av forsinkelser i innsending av isolater. Tabell 1 viser tallene fra 2008 til 2011 fordelt på fylke.

For å nå målet om å opprettholde dagens gunstige situasjon når det gjelder forekomst av MRSA i Norge, har Nasjonalt folkehelseinstitutt og Helsedirektoratet utgitt en veileder som beskriver hvordan man forholder seg til MRSA i norske helseinstitusjoner (1).
Vi ser likevel at vi har utfordringer i enkelte fylker med stor befolkningstetthet. Screeningfrekvensen fra år til år varierer i de enkelte fylker, og det er nok noe av forklaringen på økning/nedgang i antall funn. Utbrudd forårsaket av et primærtilfelle som det blir screenet rundt, kan gi store utslag på tallene for et fylke, fordi tallene i utgangspunktet er lave.
Epidemiologi
MRSA karakteriseres genotypisk med spa-typing og eventuell påvisning av Panton-Valentin-Leukocidin-gen (PVL-gen). Spa-typing er basert på en sekvenseringsanalyse av deler av et gen som ligger i x-regionen på Staphylococcus protein A-genet (spa). PVL er et cytotoxin. Tilstedeværelsen av PVL er assosiert med økt virulens. Ved behov kan enkelte isolater i tillegg testes for andre egenskaper.
Genteknologisk karakterisering av stammene gir en god epidemiologisk overvåkning og er med på å identifisere nye stammer og utbrudd på nasjonal basis. Referanselaboratoriet har etablert en web-basert løsning som gir alle deltakende laboratorier tilgang til deler av databasen, der geografisk forekomst av ulike genotyper av MRSA kan visualiseres og man kan følge spredning over tid. Ingen personidentifiserbare data inngår. Bruk av web-baserte kartløsninger for analyse av spa-typene gir en interaktiv og lettfattelig illustrasjon av den geografiske distribusjonen av MRSA-klonene (Figur 1 og 2).


Det blir også jobbet for å få til en felles nordisk kartløsning, der alle de nordiske landene leverer sine data, og utbrudd/spredning av bestemte varianter av MRSA tidlig kan fanges opp. Arbeidet mot en felles løsning har nylig startet, og målet er å presentere kartene i løpet av 2012.
Referanselaboratoriet inngår i et europeisk nettverk av laboratorier med tilsvarende nasjonale oppgaver. I 2006 deltok nettverket blant annet i kartlegging av utbredelsen av ulike genotyper av MRSA og MSSA (meticillin sensitive S. aureus) i Europa. Dette resulterte i en publikasjon og kart over situasjonen i Europa (2).
Nettverket fortsatte kartleggingen av ulike genotyper av MRSA og MSSA med en oppfølgingsstudie i 2011.
Diagnostikk av MRSA
MRSA kan påvises ved:
- Screening med spesialagar og etterfølgende bekreftelse med PCR.
- Genteknologisk undersøkelse (PCR) direkte på prøvematerialet.
- Tilfeldige funn i prøver til bakteriologisk undersøkelse der man foretar en resistensbestemmelse med etterfølgende bekreftelse med PCR.
Nytt gen
PCR av resistensgenet ”mecA” har til nå vært gullstandard for å påvise meticillinresistens hos stafylokokker. En ny variant av mecA ble imidlertid beskrevet første gang i The Lancet Infectious Diseases 3. juni 2011 (3). Det førte til at man nå også må undersøke for denne varianten hvis det er mistanke om MRSA ut fra resistensmønster eller vekst på screeningagar. Det nye genet kalles mecAlga251 og vil få navnet mecC (ikke publisert informasjon fra International Working Group on the Classification of Staphylococcal Cassette Chromosome Elements), og positive funn er å regne som MRSA.
Det nye genet har kun 70 prosents likhet med det gamle kjente genet, men har samme funksjon - det vil si at det gir resistens overfor samtlige betalaktamantibiotika (penicilliner, cephalosporiner og karbapenemer).
Mange av de mikrobiologiske laboratoriene har fått på plass en PCR også for denne varianten, og de som mangler det kan sende stammer inn til referanselaboratoriet for analyse.
Forskning
Flere prosjekter om MRSA og antibiotikaresistens er utført eller pågår ved referanselaboratoriet.
Kromogene medier
Kromogene medier er ofte brukt for screening av MRSA i en utbruddssituasjon, eller ved mistanke om smitte etter tilfeldige funn av MRSA. Det finnes flere produsenter av disse mediene, og for å teste dem ut mot ”norske” genotyper av MRSA, utførte referanselaboratoriet en sammenlignende studie i 2009, der vi testet ut fire forskjellige medier. Denne studien ble for liten i omfang til å gi konklusive tall, så vi valgte å utføre en ny studie der vi tester ut fem forskjellige medier på alle genotyper funnet i 2011. Denne studien pågår og sluttføres i mars/april 2012 (figur 3).
Resultatene fra studien vil bli presentert i form av en artikkel eller poster, eventuelt lagt ut på referanselaboratoriets hjemmesider (4) når de foreligger.
Lappediffusjon
For å overvåke resistensutviklingen hos MRSA, ble resistensbestemmelse med lappediffusjonsmetode (Figur 4) utført på 794 stammer av MRSA fra 2009, etter ny metode anbefalt av EUCAST/AFA i 2010 (5, 6). Mer enn en tredjedel av stammene var sensitive for alle 15 testede antibiotika unntatt betalaktamantibiotika. Andelen ikke-sensitive stammer, i henhold til AFAs gjeldende brytningspunkt for 2011 (7), er vist i Figur 4. Høyest andel resistens ble funnet for erytromycin, ciprofloxacin og clindamycin – lavest var mupirocin og rifampicin. Ingen stammer var resistente mot linezolid (8).
Dette prosjektet videreføres for å overvåke resistensutviklingen hos MRSA.
Glykopeptidresistens
Referanselaboratoriet har et pågående prosjekt med påvisning av resistens/heteroresistens mot glykopeptidantibiotika. Vancomycin har lenge vært ansett som svært virksomt i behandlingen av MRSA-infeksjoner, men i 1996 ble det i Japan for første gang påvist MRSA med nedsatt følsomhet for vancomycin. I ettertid har nye tilfeller dukket opp, blant annet i USA, Frankrike og Australia (9, 10).
Nedsatt følsomhet gir seg ofte uttrykk i form av heteroresistens, der hovedpopulasjonen av bakterien er sensitiv, mens noen subpopulasjoner er resistente. Heteroresistens mot vancomycin hos MRSA har vist seg å være vanskelig å påvise i laboratoriet, og kan i mange tilfeller medføre svikt i behandling av pasienten (11).
Et framtidig mål er å finne en screeningmetode som fanger opp alle MRSA med nedsatt følsomhet for glykopeptider. Over 1300 stammer fra 2009 og 2011 er så langt testet med tre typer screeningskåler. Disse skålene er tilsatt glykopeptidantibiotika (vancomycin eller teicoplanin) i ulike konsentrasjoner. Hvis en MRSA-stamme vokser, kan det bety at den er resistent mot antibiotikumet i skålen. E-tester blir i dette prosjektet brukt som referansemetode, og eventuelle stammer som er heteroresistente ut fra både skåler og E-tester blir videre satt opp på PAP-AUC (Population Analysis Profile – Area Under Curve) – en metode som regnes som ”gullstandarden” for påvisning av heteroresistens.
Av innsendte og testede isolater fra 2009 og 2011 er det foreløpig ikke påvist resistens eller heteroresistens mot glykopeptidantibiotika. Prosjektet med deteksjon av glykopeptidresistens hos MRSA videreføres i 2012.
Importerte versus ”norske” stammer
I dette prosjektet ble det gjort en sammenligning av antibiotikafølsomhet hos MRSA fra antatt innenlandssmitte og MRSA antatt ervervet utenlands. Dette var del av en bacheloroppgave ved Bioingeniørutdanningen, HiST i 2010.
Andelen ikke-sensitive stammer var signifikant høyere hos MRSA ervervet utenlands for fem av tolv testede antibiotikum. Flere ”norske” enn utenlandske stammer var sensitive for alle testede antibiotikum. I dette prosjektet ble det ikke funnet MRSA-stammer som var resistente mot linezolid eller glykopeptider.
Oppsummering
Situasjonen i Norge er fremdeles gunstig. MRSA utgjør mindre enn én prosent av Staphylococcus aureus (8). Om en ser på antall isolater som forårsaker alvorlige infeksjoner er dette tallet veldig lavt (8).
Det knyttes stor spenning til den videre utviklingen og om vi vil få en endring i situasjonen fra stor til mindre diversitet. Om en ser på utviklingen i andre land, for eksempel Storbritannia (spa-type t032) og Spania (spa-type t067), ser vi at enkelte kloner har etablert seg. Dagens overvåkning må kanskje revurderes og det må muligens innføres utvidet genotyping om vi får en lignende situasjon i Norge.
Basert på allerede testede stammer kan en antyde at de multiresistente stammene i all hovedsak er importerte. En kan anta at Norges restriktive antibiotikabruk er en medvirkende årsak til at seleksjonspresset fremdeles er lavt, og at vi fremdeles har gode behandlingsalternativer.
























